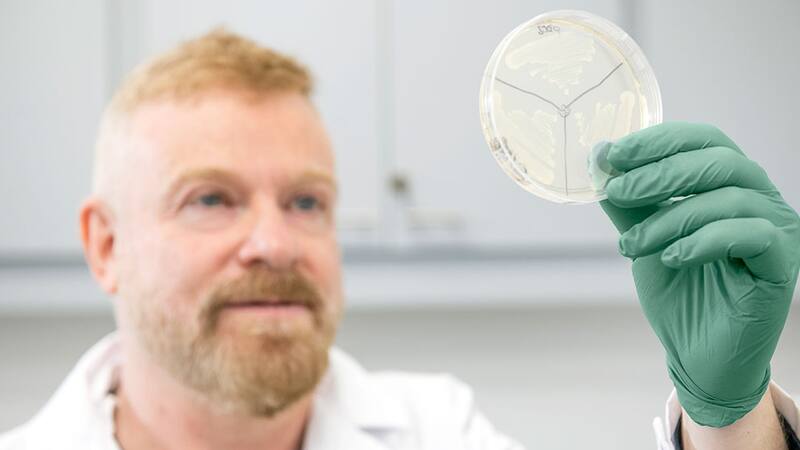
<div class="migrated-promo-image__description"><div class="migrated-promo-image__source">Fuente: https://www.conicet.gov.ar/</div></div>

Argentina se encuentra en el centro de la atención internacional en la lucha contra el cáncer, y el motivo es uno de sus científicos más destacados. Gracias a sus aportes, este científico podría llegar a ganar el Premio Nobel.
Conocé la vida de este eminente científico argentino, cuyo incansable trabajo en la investigación oncológica podría conducir a la máxima distinción en el mundo de la ciencia.
Podríamos estar a las puertas de un hito trascendental en la ciencia médica y la historia de Argentina, gracias al reconocido mundialmente Gabriel Rabinovich.
Lucha contra el cáncer: Gabriel Rabinovich sigue cosechando honores y distinciones a la espera del Premio Nobel
Gabriel Rabinovich, nacido en Córdoba el 11 de enero de 1969 (54 años), es un bioquímico y Doctor en Ciencias Químicas que se ha llevado las miradas del mundo entero ligado a la ciencia por su descubrimiento, como investigador del CONICET.
Tras un trabajo incansable, Rabinovich llegó a conocer los secretos de la Galectina-1, una proteína que desempeña un papel fundamental tanto en enfermedades autoinmunes como en el cáncer, lo que lo ha situado en la cúspide de la ciencia y medicina mundial, cerca del Premio Nobel.

A lo largo de su carrera, ha publicado más de 260 trabajos y ha sido citado en más de 15.000 ocasiones. Sus investigaciones científicas se han presentado en las revistas científicas más prestigiosas del mundo, como Cell, Nature, y PNAS, entre muchas más.
A lo largo de su carrera, Rabinovich ha sido galardonado con numerosos premios en Argentina y el mundo, incluyendo el Premio Houssay Trayectoria, Premio Investigador de la Nación Argentina - Presidencia de la Nación y el Premio Bunge & Born a la Trayectoria.
Recientemente, Gabriel Rabinovich, se hizo también con el Konex de Brillante, el mayor galardón Konex por sus avances y aportes el pasado 31 de octubre. Esto sugiere que el Premio Nobel está más cerca de lo que podría imaginarse.
¿Cuál fue el descubrimiento en Lucha contra el cáncer de Gabriel Rabinovich, el científico argentina que podría ganar un Premio Nobel?
Gabriel Rabinovich identificó y desentrañó el secreto de la Galectina-1, una proteína fundamental en el organismo. Esta proteína se encarga de regular el sistema inmunológico. En particular, descubrió que desempeña un papel clave en enfermedades autoinmunes.
Cuando la Galectina-1 escasea en el cuerpo, el sistema inmunológico puede reaccionar de manera desmedida, lo que conduce a enfermedades autoinmunes.
Galectina-1: protagonista en el cáncer
A su vez, en el caso del cáncer, los tumores producen Galectina-1 en abundancia. Esta proteína actúa como un "alimento" para el crecimiento de los tumores, permitiéndoles desarrollarse y, en algunos casos, propagarse por todo el cuerpo.
Esto se debe al papel de la Galectina-1 en la angiogénesis, que es el proceso de formación de nuevos vasos sanguíneos que alimentan el crecimiento del tumor.
El trabajo de Rabinovich no se ha limitado a identificar esta proteína y sus funciones, sino que buscó utilizar este conocimiento para desarrollar tratamientos innovadores y medicamentos como variante a la Galectina-1, acercándose a la cura contra el cáncer.


